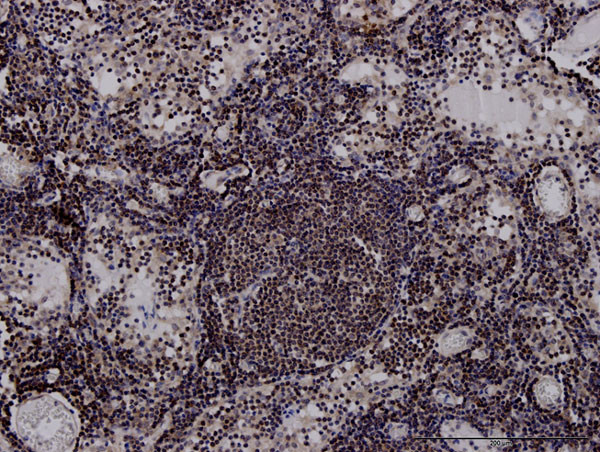
HLA-DPB1 Antibody in Immunohistochemistry (Paraffin) (IHC (P))

Search
Abnova
HLA-DPB1 Monoclonal Antibody (6C6)
{{$productOrderCtrl.translations['antibody.pdp.commerceCard.promotion.promotions']}}
{{$productOrderCtrl.translations['antibody.pdp.commerceCard.promotion.viewpromo']}}
{{$productOrderCtrl.translations['antibody.pdp.commerceCard.promotion.promocode']}}: {{promo.promoCode}} {{promo.promoTitle}} {{promo.promoDescription}}. {{$productOrderCtrl.translations['antibody.pdp.commerceCard.promotion.learnmore']}}
产品信息
H00003115-M01J
宿主/亚型
分类
类型
克隆号
抗原
偶联物
形式
浓度
规格
保存条件
运输条件
产品详细信息
Sequence of this protein is as follows: MMVLQVSAAP RTVALTALLM VLLTSVVQGR ATPENYVYQG RQECYAFNGT QRFLERYIYN REEYARFDSD VGEFRAVTEL GRPAAEYWNS QKDILEEKRA VPDRVCRHNY ELDEAVTLQR RVQPKVNVSP SKKGPLQHHN LLVCHVTDFY PGSIQVRWFL NGQEETAGVV STNLIRNGDW TFQILVMLEM TPQQGDVYIC QVEHTSLDSP VTVEWKAQSD SAQSKTLTGA GGFVLGLIIC GVGIFMHRRS KKVQRGSA
Cell culture grade monoclonal antibodies are obtained by purifying "hybridoma culture medium" which completely eliminates any contamination of mice. They have high affinity, high purity, and no contamination.
靶标信息
HLA-DPB belongs to the HLA class II beta chain paralogues. This class II molecule is a heterodimer consisting of an alpha (DPA) and a beta chain (DPB), both anchored in the membrane. It plays a central role in the immune system by presenting peptides derived from extracellular proteins. Class II molecules are expressed in antigen presenting cells (APC: B lymphocytes, dendritic cells, macrophages). The beta chain is approximately 26-28 kDa and its gene contains 6 exons. Exon one encodes the leader peptide, exons 2 and 3 encode the two extracellular domains, exon 4 encodes the transmembrane domain and exon 5 encodes the cytoplasmic tail. Within the DP molecule both the alpha chain and the beta chain contain the polymorphisms specifying the peptide binding specificities, resulting in up to 4 different molecules.
HLA and MHC antibodies play a significant role in Immunopeptidomics, facilitating the identification and characterization of neoantigens through high-performance liquid chromatography coupled to tandem Mass Spectrometry.
仅用于科研。不用于诊断过程。未经明确授权不得转售。